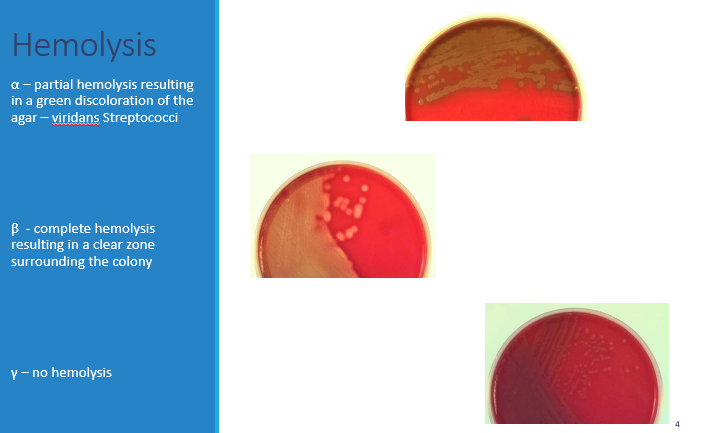

Define viridans Streptococci
Alpha hemolytic Strept
Which group(s) of Strept are beta hemolytic?
Beta hemolytic strept: groups A and B
Alpha hemolytic strept can be further classified as optochin positive or negative. Which Strept spp fall into either category?
Optochin positive: Streptococcus pneumoniae
Optochin negative: Viridans streptococci

If you observe gamma hemolysis on a Strept plate and you conduct a PYR test, what bacteria are indicated by a +ve or -ve result?
Gamma hemolysis: either enterococcus (if PYR +ve) or non-enterococcus Strept spp (if PYR -ve)

Describe one characteristic of each of the classes of Strept (Groups A, B, C, D, F and G)
◦Group A Streptococcus (GAS): most common clinical infection
◦Group B Streptococcus: important pathogen in neonates
◦Group C: mostly zoonotic
◦Group D: mostly enterococci
◦Group F: Streptococcus anginosus or S. milleri group
◦Group G: typically found in animals
The main bacteria in Group A Strept is ___
This bacteria is responsible for two general types of infection, suppurative and non-suppurative. Describe each.
Group A Strept: Same thing as Strept pyogenes
Suppurative – pus producing; pharyngitis and skin infections
Non suppurative – more immunologically mediated; rheumatic fever and rheumatic heart disease, acute glomerulonephritis
The main virulence factor in Group A Strept is ___ which is strongly antiphagocytic
M protein: very antiphygocytic (way of escaping immunity) - binds serum proteins (e.g. factor H) that inhibit activation of alternative complement components
Also elicits opsonic antibodies
The M protein also helps Strept to adhere to the host cells. Which particular cells does the protein bind to?
How is the M protein implicated in cardiac complications resulting from previous Strept infection?
Binds numerous serum proteins and CD46 on keratinocytes
Certain types can generate antibodies that react with cardiac myosin and sarcolemma
M protein sticks out of the membrane and at the end of the protein is where there is genetic diversity
Antibodies will be specific to any particular M protein
M protein binds to keratinocytes and causes skin and soft tissue infections
Some M proteins can develop antibodies that can cross react with cardiac myosin (attack cardiac tissue) and sarcolemma
Name two other virulence factors for Strept (hint: these are part of Strept’s structure i.e. not secreted)
Capsule and surface adhesins
**the capsule is made of hyaluronic acid, is non-immunogenic and anti-phagocytic**
Describe the functions of the following surface adhesins:
◦Lipoteichoic acid
◦M protein
◦Protein F
◦Lipoteichoic acid – binding to host cells
◦M protein – bind to keratinocytes
◦Protein F – bind to fibronectin and mucosal cells** (Strept throat mediated by protein F mucosal binding)
___ and ___ are two hemolysins produced by Strept
Hemolysins (RBC lysis):
◦Streptolysin O (antibodies to this suggest previous infection)
◦Streptolysin S
Describe how Streptococcal pyrogenic exotoxins contribute to virulence in Streptococcus
◦SpeA, SpeC
◦Encoded by bacteriophages
◦Superantigens (cause cytokine storm and dramatic immune response)
◦Responsible for characteristic features of Scarlet Fever and Streptococcal Toxic Shock Syndrome
◦HLA dependent response**
◦SpeB
Describe the function of the following enzymes in Strept virulence:
◦DNAses
◦Hyaluronidase
◦Streptokinase
◦DNAses
◦Hyaluronidase
◦Streptokinase: Degrades fibrin and used as a medication (clot busters)
How does Strept evade the innate immune response?
◦C5a peptidase: disrupts complement activity
◦SpeB: cleaves IgG
Where on/in the body does one get colonized with Strept?
How is Strept transmitted from person to person?
Multiple episodes of transient colonization of oropharynx and skin
Transmitted person to person via oral secretions or contact with skin lesions
Suppurative diseases caused by Strept include ___ manifesting as Scarlet fever, and pneumonia, which is uncommon
Skin diseases causes by Strept include Impetigo, ___ (form of cellulitis), necrotizing fasciitis and ____ syndrome
Suppurative diseases caused by Strept include pharyngitis manifesting as Scarlet fever, and pneumonia, which is uncommon
Skin diseases causes by Strept include impetigo, erysipelas, necrotizing fasciitis and Streptococcal toxic shock syndrome
What are the clinical features of pharyngitis (esp those that point to a bacterial infection and NOT a viral infection)?
◦Fever
◦Absence of cough
◦Purulent exudate – pus on tonsils
◦Cervical lymphadenopathy

How do you Dx Strept and what is the best course of treatment?
Dx: Rapid Strept test
**won’t be necessary if pt has symptoms of a viral thing
If strept Ag test is negative but they’re symptomatic, do a culture. If culture is +ve, give antibiotics. If –ve, no treatment. Most folks get better w/o antibiotics but we treat b/c prevention of non-suppurative cmplxns
Also responsive to Penicillin. Macrolides or clindamycin for penicillin allergy
Describe the condition below and what causes it

Scarlet fever
** Uncommon manifestation of acute infection (usually pharyngitis)
Manifestation of SpeA or SpeC
Rash begins on trunk
Capillary fragility:
◦Accentuated in skin folds
◦Petechiae elicited with blood pressure cuff
Subsequent desquamation
Describe the condition below and what causes it

Erysipelas: Form of cellulitis
Highly characteristic of β-hemolytic Streptococcus
Bright erythema
Edema
Sharp raised edges
Regional lymphadenopathy
Systemic symptoms
Clinical symptoms to look for when suspecting Strept mediated necrotizing fasciitis include ___, septic shock in association with cellulitis, ___ bullae and dishwater drainage
◦Pain out of proportion for clinical findings
◦Septic shock in association with cellulitis
◦Hemorrhagic bullae
◦Dishwater drainage (if the bullae pop and it looks like dirty dishwater)

Streptococcal toxic shock syndrome is due to ___ and results in multi-organ system dysfunction, rash, fever, hypotension and shock
Streptococcal toxic shock syndrome is due to pyognic exotoxins (SpeA and SpeC) and results in multi-organ system dysfunction, rash, fever, hypotension and shock

How does Strept infection lead to rheumatic fever and acute glomerulonephritis?
Rheumatic fever and rheumatic heart disease
◦Molecular mimicry – specific M proteins have epitopes shared with cardiac antigens
◦Infiltration of T lymphocytes into heart tissue, inflammatory cytokines, cardiac valve lesions
◦Associated with certain HLA-DR alleles
Acute glomerulonephritis
◦Likely due to deposition of immune complexes in kidney
◦Activation of enzymes that damage glomerular basement membrane, with protein loss and decreased renal function
Acute rheumatic fever has several major criteria, including: ___ ,carditis, ___, erythema marginatum, ___
Minor criteria include arthralgia, fever, elevated ___ or ESR, ___ degree heart block
Acute Rheumatic fever:
Clinical syndrome
◦Major criteria (2 or 1 plus 2 minor)
◦Polyarthritis, carditis, chorea, erythema marginatum, subcutaneous nodules (remember JONES from Sketchy)
◦Minor criteria
◦Arthralgia, fever, elevated C-reactive protein or ESR, 1st degree heart block
◦Evidence of recent infection
Culture, antigen or serology (can use ASO)



